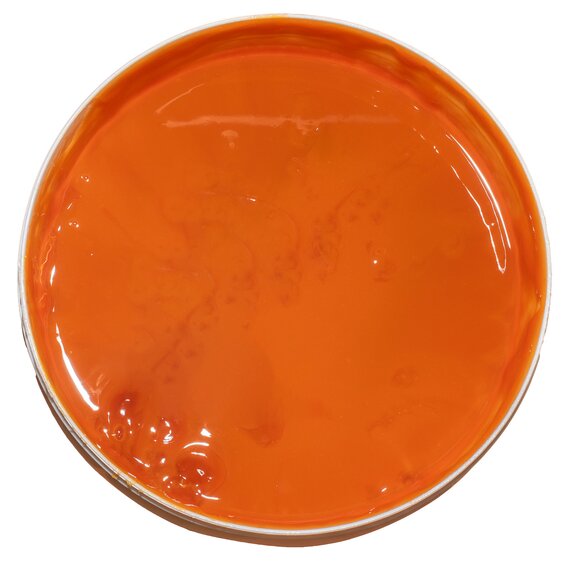
Аромпаста Aromitalia Манго Альфонсо 3.5 кг, изображение 6

Аромпаста Aromitalia Манго Альфонсо 3.5 кг
700
Минимальный заказ
Минимальная сумма заказа 1000 грн
Доставка
- — Бесплатная курьерская доставка по Киеву (с 12 до 19) при заказе от 1500 грн
- — Доставка Новой Почтой - согласно тарифов перевозчика
- — Адресная доставка Новой Почты - согласно тарифов перевозчика
- Все о товаре
- Описание
- Характеристики
- Вариации товара
Описание
Паста со вкусом манго, ценного сорта Альфонсо. Благодаря наличию настоящей мякоти манго (20%) ваш продукт приобретет сладкие экзотические оттенки и свежий сливочный вкус. Весь вкус тропиков в вашем изделии.
Дозировка: 80 г на 1 кг.
Срок годности: 36 мес.
Концентрированные Аромпасты необходимы для придания вкусу, цвету и аромату десертам, муссам, кремам, ганашам, бисквитам, мороженому, коктейлям, начинкам, мармеладу, зефиру, соусам, а также сдобному тесту.
Преимущества Аромпаст:
- Имеют гармоничный насыщенный вкус
- Имеют широкий спектр применения
- Полностью готовы к использованию
- Имеют длительный срок хранения
- Простые в использовании, хорошо перемешиваются с другими ингредиентами.
- Экономические (вследствие высокой концентрации пасты)
- Содержат в своем составе натуральные ингредиенты
Характеристики
Вариации товара